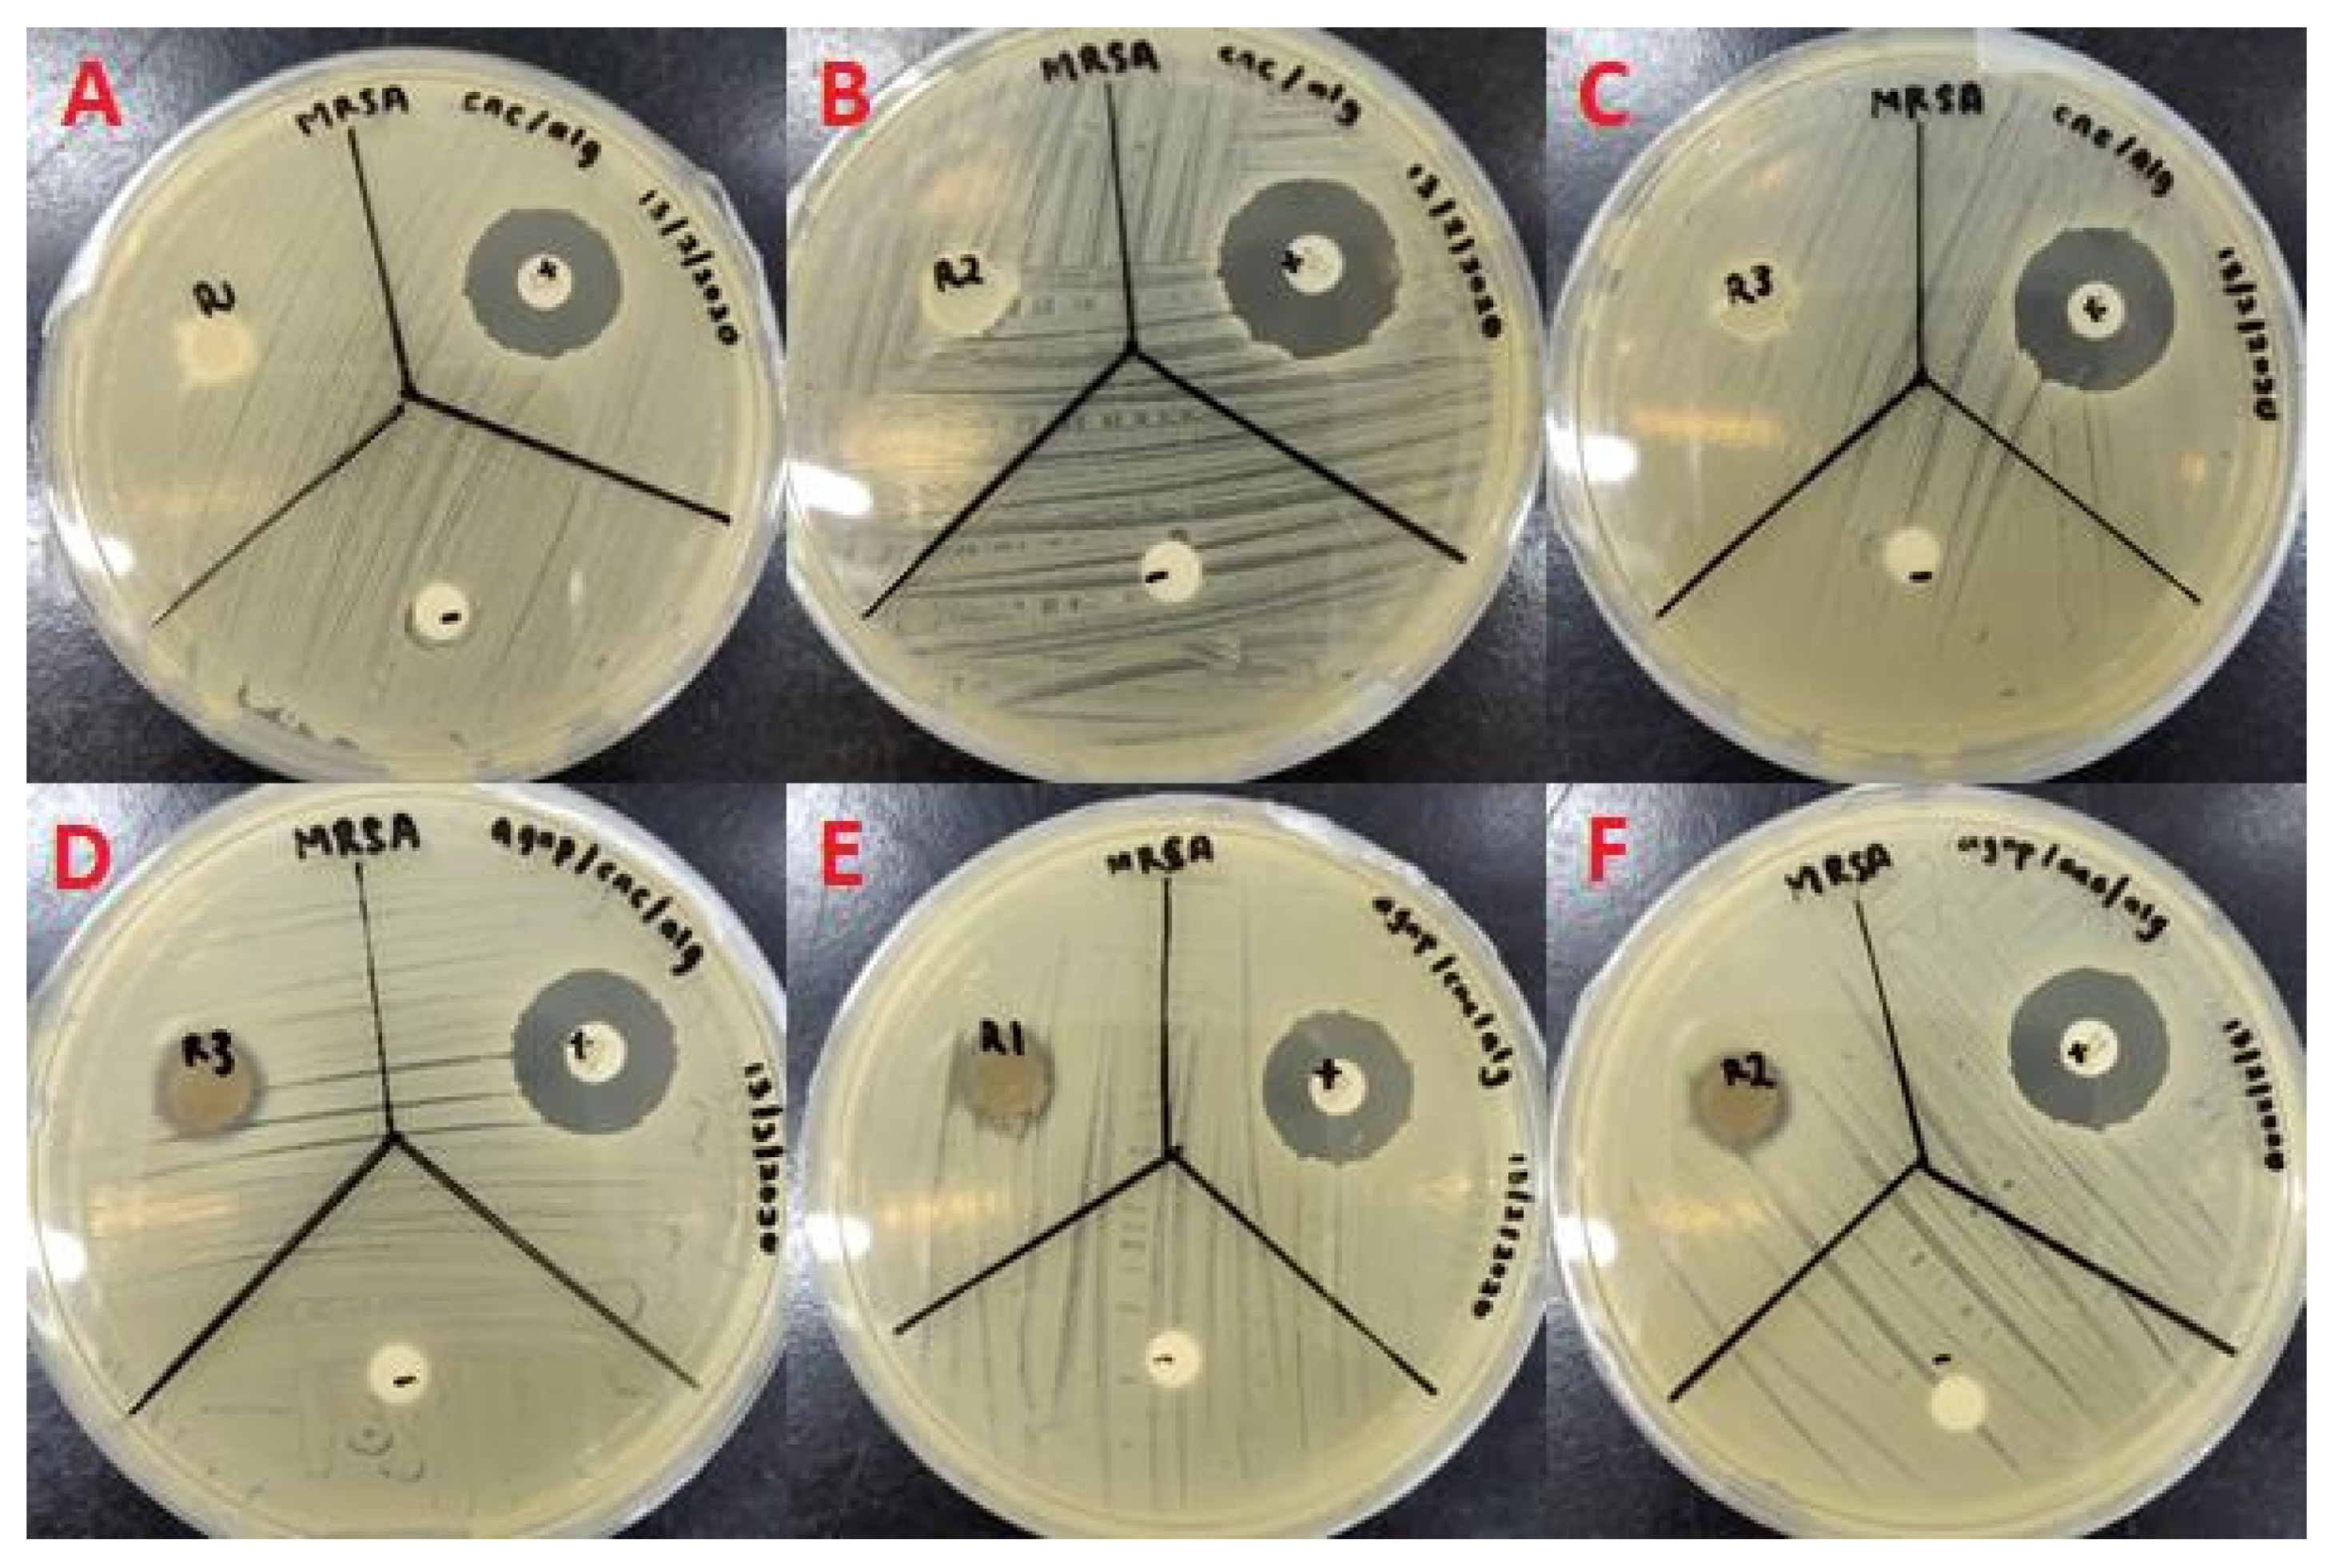
Molecules 26 06414 g011

Study of Antibacterial and Anticancer Properties of bioAgNPs Synthesized Using Streptomyces sp. PBD-311B and the Application of bioAgNP-CNC/Alg as an Antibacterial Hydrogel Film against P. aeruginosa USM-AR2 and MRSA
Abstract
:1. Introduction
2. Results and Discussion
2.1. Extracellular Biosynthesis of bioAgNPs
2.2. Characterization of the Shape, Size, and Crystallinity of the bioAgNPs
2.3. Antibacterial Activity of bioAgNPs
2.4. Cytotoxicity Analysis of bioAgNPs
2.5. Formation of CNC/Alg and bioAgNP/CNC/Alg Films
2.6. Application of bioAgNP/CNC/Alg Hydrogel Film
3. Materials and Methods
3.1. Materials
3.1.1. Chemical Reagents
3.1.2. Bacterial Strains and Human Cell Lines
3.2. Methods
3.2.1. Cultivation of Streptomyces sp. PBD-311B
3.2.2. Extracellular Biosynthesis of AgNPs
3.2.3. UV-Vis Spectroscopy Analysis of bioAgNPs
3.2.4. Transmission Electron Microscopy (TEM) Analysis
3.2.5. X-ray Diffraction (XRD) Analysis
3.2.6. Antibacterial Testing Using the Tetrazolium Microplate Assay (TEMA)
3.2.7. Observation of bioAgNPs’ Inhibition Mechanism Using TEM
3.2.8. Cytotoxicity Analysis of bioAgNPs
3.2.9. Preparation of Cellulose Nanocrystals (CNCs) from Oil Palm Trunk
3.2.10. Formation of the bioAgNP/CNC/Alg Hydrogel Film
3.2.11. Fourier Transform Infrared Spectroscopy (FTIR) Analysis
3.2.12. Disc Diffusion Test of the bioAgNP/CNC/Alg Hydrogel Film
3.2.13. Statistical Analysis
4. Conclusions
Author Contributions
Funding
Institutional Review Board Statement
Informed Consent Statement
Data Availability Statement
Acknowledgments
Conflicts of Interest
Sample Availability
References
- Lamaming, J.; Hashim, R.; Sulaiman, O.; Leh, C.P.; Sugimoto, T.; Nordin, N.A. Cellulose nanocrystals isolated from oil palm trunk. Carbohydr. Polym. 2015, 127, 202–208. [Google Scholar] [CrossRef]
- Arora, S.; Jain, J.; Rajwade, J.; Paknikar, K. Cellular responses induced by silver nanoparticles: In vitro studies. Toxicol. Lett. 2008, 179, 93–100. [Google Scholar] [CrossRef]
- Panáček, A.; Smékalová, M.; Kilianová, M.; Prucek, R.; Bogdanová, K.; Večeřová, R.; Kolář, M.; Havrdová, M.; Płaza, G.A.; Chojniak, J.; et al. Strong and Nonspecific Synergistic Antibacterial Efficiency of Antibiotics Combined with Silver Nanoparticles at Very Low Concentrations Showing No Cytotoxic Effect. Molecules 2015, 21, 26. [Google Scholar] [CrossRef] [PubMed] [Green Version]
- Eid, A.M.; Fouda, A.; Niedbała, G.; Hassan, S.E.-D.; Salem, S.S.; Abdo, A.M.; Hetta, H.F.; Shaheen, T.I. Endophytic Streptomyces laurentii Mediated Green Synthesis of Ag-NPs with Antibacterial and Anticancer Properties for Developing Functional Textile Fabric Properties. Antibiotics 2020, 9, 641. [Google Scholar] [CrossRef] [PubMed]
- Hashim, N.; Paramasivam, M.; Tan, J.S.; Kernain, D.; Hussin, M.H.; Brosse, N.; Gambier, F.; Raja, P.B. Green mode synthesis of silver nanoparticles using Vitis vinifera’s tannin and screening its antimicrobial activity/apoptotic potential versus cancer cells. Mater. Today Commun. 2020, 25, 2352–4928. [Google Scholar] [CrossRef]
- Zulkifli, N.I.; Muhamad, M.; Zain, N.N.M.; Tan, W.-N.; Yahaya, N.; Bustami, Y.; Aziz, A.A.; Kamal, N.N.S.N.M. A Bottom-Up Synthesis Approach to Silver Nanoparticles Induces Anti-Proliferative and Apoptotic Activities Against MCF-7, MCF-7/TAMR-1 and MCF-10A Human Breast Cell Lines. Molecules 2020, 25, 4332. [Google Scholar] [CrossRef] [PubMed]
- Chopade, B.A.; Singh, R.; Wagh, P.; Wadhwani, S.; Gaidhani, S.; Kumbhar, A.; Bellare, J. Synthesis, optimization, and characterization of silver nanoparticles from Acinetobacter calcoaceticus and their enhanced antibacterial activity when combined with antibiotics. Int. J. Nanomed. 2013, 8, 4277–4290. [Google Scholar] [CrossRef] [PubMed] [Green Version]
- Railean-Plugaru, V.; Pomastowski, P.; Wypij, M.; Szultka-Młyńska, M.; Rafinska, K.; Golinska, P.; Dahm, H.; Buszewski, B. Study of silver nanoparticles synthesized by acidophilic strain of Actinobacteria isolated from the of Picea sitchensis forest soil. J. Appl. Microbiol. 2016, 120, 1250–1263. [Google Scholar] [CrossRef] [Green Version]
- Akter, M.; Sikder, T.; Rahman, M.; Ullah, A.K.M.A.; Hossain, K.F.B.; Banik, S.; Hosokawa, T.; Saito, T.; Kurasaki, M. A systematic review on silver nanoparticles-induced cytotoxicity: Physicochemical properties and perspectives. J. Adv. Res. 2017, 9, 1–16. [Google Scholar] [CrossRef]
- Składanowski, M.; Golinska, P.; Rudnicka, K.; Dahm, H.; Rai, M. Evaluation of cytotoxicity, immune compatibility and antibacterial activity of biogenic silver nanoparticles. Med. Microbiol. Immunol. 2016, 205, 603–613. [Google Scholar] [CrossRef] [Green Version]
- Iravani, S.; Korbekandi, H.; Mirmohammadi, S.; Zolfaghari, B. Synthesis of silver nanoparticles: Chemical, physical and biological methods. Res. Pharm. Sci. 2015, 9, 385–406. [Google Scholar]
- Ahmad, A.; Mukherjee, P.; Senapati, S.; Mandal, D.; Khan, M.; Kumar, R.; Sastry, M. Extracellular biosynthesis of silver nanoparticles using the fungus Fusarium oxysporum. Colloids Surf. B Biointerfaces 2003, 28, 313–318. [Google Scholar] [CrossRef]
- Bhainsa, K.C.; D’Souza, S. Extracellular biosynthesis of silver nanoparticles using the fungus Aspergillus fumigatus. Colloids Surf. B Biointerfaces 2006, 47, 160–164. [Google Scholar] [CrossRef]
- Jain, S.; Saxena, N.; Sharma, M.K.; Chatterjee, S. Metal nanoparticles and medicinal plants: Present status and future prospects in cancer therapy. Mater. Today Proc. 2020, 31, 662–673. [Google Scholar] [CrossRef]
- Karthiga, P.; RajeshKumar, S.; Annadurai, G. Mechanism of Larvicidal Activity of Antimicrobial Silver Nanoparticles Synthesized Using Garcinia mangostana Bark Extract. J. Clust. Sci. 2018, 29, 1233–1241. [Google Scholar] [CrossRef]
- Gnanajobitha, G.; Paulkumar, K.; Vanaja, M.; RajeshKumar, S.; Malarkodi, C.; Annadurai, G.; Kannan, C. Fruit-mediated synthesis of silver nanoparticles using Vitis vinifera and evaluation of their antimicrobial efficacy. J. Nanostruct. Chem. 2013, 3, 67. [Google Scholar] [CrossRef] [Green Version]
- Shahverdi, A.R.; Minaeian, S.; Shahverdi, H.R.; Jamalifar, H.; Nohi, A.-A. Rapid synthesis of silver nanoparticles using culture supernatants of Enterobacteria: A novel biological approach. Process. Biochem. 2007, 42, 919–923. [Google Scholar] [CrossRef]
- Kalishwaralal, K.; Deepak, V.; Pandian, S.R.K.; Nellaiah, H.; Sangiliyandi, G. Extracellular biosynthesis of silver nanoparticles by the culture supernatant of Bacillus licheniformis. Mater. Lett. 2008, 62, 4411–4413. [Google Scholar] [CrossRef]
- Alani, F.; Moo-Young, M.; Anderson, W. Biosynthesis of silver nanoparticles by a new strain of Streptomyces sp. compared with Aspergillus fumigatus. World J. Microbiol. Biotechnol. 2012, 28, 1081–1086. [Google Scholar] [CrossRef]
- Sahana, T.G.; Rekha, P. Biopolymers: Applications in wound healing and skin tissue engineering. Mol. Biol. Rep. 2018, 45, 2857–2867. [Google Scholar] [CrossRef]
- Edwards, R.; Harding, K. Bacteria and wound healing. Curr. Opin. Infect. Dis. 2004, 17, 91–96. [Google Scholar] [CrossRef] [PubMed]
- Lustosa, A.K.M.F.; Oliveira, A.C.D.J.; Quelemes, P.V.; Plácido, A.; Da Silva, F.V.; Oliveira, I.S.; De Almeida, M.P.; Amorim, A.D.G.N.; Delerue-Matos, C.; Oliveira, R.D.C.M.D.; et al. In Situ Synthesis of Silver Nanoparticles in a Hydrogel of Carboxymethyl Cellulose with Phthalated-Cashew Gum as a Promising Antibacterial and Healing Agent. Int. J. Mol. Sci. 2017, 18, 2399. [Google Scholar] [CrossRef] [PubMed] [Green Version]
- Nguyen, T.D.; Nguyen, T.T.; Ly, K.; Tran, H.; Nguyen, T.T.N.; Vo, M.T.; Ho, H.M.; Dang, N.T.N.; Vo, V.T.; Nguyen, D.H. In Vivo Study of the Antibacterial Chitosan/Polyvinyl Alcohol Loaded with Silver Nanoparticle Hydrogel for Wound Healing Applications. Int. J. Polym. Sci. 2019, 2019, 7382717. [Google Scholar] [CrossRef]
- Tang, J.; Sisler, J.; Grishkewich, N.; Tam, K.C. Functionalization of cellulose nanocrystals for advanced applications. J. Colloid Interface Sci. 2017, 494, 397–409. [Google Scholar] [CrossRef] [PubMed]
- Huq, T.; Salmieri, S.; Khan, A.; Khan, R.A.; Le Tien, C.; Riedl, B.; Fraschini, C.; Bouchard, J.; Uribe-Calderon, J.; Kamal, M.R.; et al. Nanocrystalline cellulose (NCC) reinforced alginate based biodegradable nanocomposite film. Carbohydr. Polym. 2012, 90, 1757–1763. [Google Scholar] [CrossRef] [PubMed]
- Sofla, M.R.K.; Brown, R.J.; Tsuzuki, T.; Rainey, T.J. A comparison of cellulose nanocrystals and cellulose nanofibres extracted from bagasse using acid and ball milling methods. Adv. Nat. Sci. Nanosci. Nanotechnol. 2016, 7, 035004. [Google Scholar] [CrossRef]
- Cai, J.; Liu, S.; Feng, J.; Kimura, S.; Wada, M.; Kuga, S.; Zhang, L. Cellulose-Silica Nanocomposite Aerogels by In Situ Formation of Silica in Cellulose Gel. Angew. Chem. Int. Ed. Engl. 2012, 51, 2076–2079. [Google Scholar] [CrossRef] [PubMed]
- Yang, K.; Han, Q.; Chen, B.; Zheng, Y.; Zhang, K.; Li, Q.; Wang, J. Antimicrobial hydrogels: Promising materials for medical application. Int. J. Nanomed. 2018, 13, 2217–2263. [Google Scholar] [CrossRef] [Green Version]
- Dhand, V.; Soumya, L.; Bharadwaj, S.; Chakra, S.; Bhatt, D.; Sreedhar, B. Green synthesis of silver nanoparticles using Coffea arabica seed extract and its antibacterial activity. Mater. Sci. Eng. C Mater. Biol. Appl. 2016, 58, 36–43. [Google Scholar] [CrossRef]
- Das, R.; Nath, S.S.; Chakdar, D.; Gope, G.; Bhattacharjee, R. Synthesis of silver nanoparticles and their optical properties. J. Exp. Nanosci. 2010, 5, 357–362. [Google Scholar] [CrossRef] [Green Version]
- Maciollek, A.; Ritter, H. One pot synthesis of silver nanoparticles using a cyclodextrin containing polymer as reductant and stabilizer. Beilstein J. Nanotechnol. 2014, 5, 380–385. [Google Scholar] [CrossRef] [PubMed] [Green Version]
- Wang, W.; Yang, M.; Wang, Z.; Yan, J.; Liu, C. Silver nanoparticle aggregates by room temperature electron reduction: Preparation and characterization. RSC Adv. 2014, 4, 63079–63084. [Google Scholar] [CrossRef]
- Bélteky, P.; Rónavári, A.; Igaz, N.; Szerencsés, B.; Tóth, I.Y.; Pfeiffer, I.; Kiricsi, M.; Kónya, Z. Silver nanoparticles: Aggregation behavior in biorelevant conditions and its impact on biological activity. Int. J. Nanomed. 2019, 14, 667–687. [Google Scholar] [CrossRef] [Green Version]
- Karthik, L.; Kumar, G.; Kirthi, A.V.; Rahuman, A.A.; Rao, K.V.B. Streptomyces sp. LK3 mediated synthesis of silver nanoparticles and its biomedical application. Bioprocess. Biosyst. Eng. 2014, 37, 261–267. [Google Scholar] [CrossRef]
- Sadhasivam, S.; Shanmugam, P.; Yun, K. Biosynthesis of silver nanoparticles by Streptomyces hygroscopicus and antimicrobial activity against medically important pathogenic microorganisms. Colloids Surf. B Biointerfaces 2010, 81, 358–362. [Google Scholar] [CrossRef] [PubMed]
- Dakal, T.C.; Kumar, A.; Majumdar, R.S.; Yadav, V. Mechanistic Basis of Antimicrobial Actions of Silver Nanoparticles. Front. Microbiol. 2016, 7, 1831. [Google Scholar] [CrossRef] [Green Version]
- Prakasham, R.S.; Buddana, S.K.; Yannam, S.K.; Guntuku, G.S. Characterization of Silver Nanoparticles Synthesized by Using Marine Isolate Streptomyces albidoflavus. J. Microbiol. Biotechnol. 2012, 22, 614–621. [Google Scholar] [CrossRef] [PubMed] [Green Version]
- Zonooz, N.F.; Salouti, M. Extracellular biosynthesis of silver nanoparticles using cell filtrate of Streptomyces sp. ERI-3. Sci. Iran. 2011, 18, 1631–1635. [Google Scholar] [CrossRef] [Green Version]
- Shrestha, A.; Zhilong, S.; Gee, N.K.; Kishen, A. Nanoparticulates for Antibiofilm Treatment and Effect of Aging on Its Antibacterial Activity. J. Endod. 2010, 36, 1030–1035. [Google Scholar] [CrossRef]
- Rai, M.; Deshmukh, S.; Ingle, A.; Gade, A. Silver nanoparticles: The powerful nanoweapon against multidrug-resistant bacteria. J. Appl. Microbiol. 2012, 112, 841–852. [Google Scholar] [CrossRef] [PubMed]
- Breijyeh, Z.; Jubeh, B.; Karaman, R. Resistance of Gram-Negative Bacteria to Current Antibacterial Agents and Approaches to Resolve It. Molecules 2020, 25, 1340. [Google Scholar] [CrossRef] [PubMed] [Green Version]
- Wypij, M.; Czarnecka, J.; Świecimska, M.; Dahm, H.; Rai, M.; Golinska, P. Synthesis, characterization and evaluation of antimicrobial and cytotoxic activities of biogenic silver nanoparticles synthesized from Streptomyces xinghaiensis OF1 strain. World J. Microbiol. Biotechnol. 2018, 34, 23. [Google Scholar] [CrossRef] [Green Version]
- Deshmukh, S.; Patil, S.; Mullani, S.; Delekar, S. Silver nanoparticles as an effective disinfectant: A review. Mater. Sci. Eng. C Mater. Biol. Appl. 2019, 97, 954–965. [Google Scholar] [CrossRef]
- Foxley, M.A.; Friedline, A.W.; Jensen, J.M.; Nimmo, S.L.; Scull, E.M.; King, J.B.; Strange, S.; Xiao, M.T.; Smith, B.E.; Iii, K.J.T.; et al. Efficacy of ampicillin against methicillin-resistant Staphylococcus aureus restored through synergy with branched poly(ethylenimine). J. Antibiot. 2016, 69, 871–878. [Google Scholar] [CrossRef] [PubMed] [Green Version]
- Campbell, J.; Singh, A.K.; Swoboda, J.G.; Gilmore, M.S.; Wilkinson, B.J.; Walker, S. An Antibiotic That Inhibits a Late Step in Wall Teichoic Acid Biosynthesis Induces the Cell Wall Stress Stimulon in Staphylococcus aureus. Antimicrob. Agents Chemother. 2012, 56, 1810–1820. [Google Scholar] [CrossRef] [PubMed] [Green Version]
- Wei, H.J.; Awang, M.S.; Dyana, N.; Kernain, D.; Bustami, Y. Evaluation of anti bacteria effects of citrate-reduced silver nanoparticles in Staphylococcus aureus and Escherichia coli. Int. J. Res. Pharm. Sci. 2019, 10, 3636–3643. [Google Scholar] [CrossRef]
- Pal, S.; Tak, Y.K.; Song, J.M. Does the Antibacterial Activity of Silver Nanoparticles Depend on the Shape of the Nanoparticle? A Study of the Gram-Negative Bacterium Escherichia coli. Appl. Environ. Microbiol. 2007, 73, 1712–1720. [Google Scholar] [CrossRef] [Green Version]
- Rai, M.; Yadav, A.; Gade, A. Silver nanoparticles as a new generation of antimicrobials. Biotechnol. Adv. 2009, 27, 76–83. [Google Scholar] [CrossRef] [PubMed]
- AshaRani, P.V.; Mun, G.L.K.; Hande, M.P.; Valiyaveettil, S. Cytotoxicity and Genotoxicity of Silver Nanoparticles in Human Cells. ACS Nano 2009, 3, 279–290. [Google Scholar] [CrossRef]
- Perde-Schrepler, M.; Florea, A.; Brie, I.; Virag, P.; Fischer-Fodor, E.; Vâlcan, A.; Gurzau, E.; Lisencu, C.; Maniu, A. Size-Dependent Cytotoxicity and Genotoxicity of Silver Nanoparticles in Cochlear Cells In Vitro. J. Nanomater. 2019, 2019, 1–12. [Google Scholar] [CrossRef] [Green Version]
- Yadav, M.; Liu, Y.-K.; Chiu, F.-C. Fabrication of Cellulose Nanocrystal/Silver/Alginate Bionanocomposite Films with Enhanced Mechanical and Barrier Properties for Food Packaging Application. Nanomaterials 2019, 9, 1523. [Google Scholar] [CrossRef] [PubMed] [Green Version]
- Monowar, T.; Rahman, M.S.; Bhore, S.J.; Raju, G.; Sathasivam, K.V. Silver Nanoparticles Synthesized by Using the Endophytic Bacterium Pantoea ananatis are Promising Antimicrobial Agents against Multidrug Resistant Bacteria. Molecules 2018, 23, 3220. [Google Scholar] [CrossRef] [PubMed] [Green Version]
- Devi, G.K.; Kumar, P.S.; Kumar, K.S. Green synthesis of novel silver nanocomposite hydrogel based on sodium alginate as an efficient biosorbent for the dye wastewater treatment: Prediction of isotherm and kinetic parameters. Desalination Water Treat. 2016, 57, 6090259. [Google Scholar] [CrossRef]
- Sastry, M.; Ahmad, A.; Islam Khan, M.; Kumar, R. Biosynthesis of metal nanoparticles using fungi and actinomycete. Curr. Sci. 2003, 85, 162–170. [Google Scholar]
- Homayouni, A.; Ehsani, M.; Azizi, A.; Yarmand, M.S.; Razavi, S. Effect of lecithin and calcium chloride solution on the microencapsulation process yield of calcium alginate beads. Iran. Polym. J. 2007, 16, 597–606. Available online: https://www.sid.ir/en/journal/ViewPaper.aspx?id=95979 (accessed on 2 February 2020).
- Lee, H.V.; Hamid, S.B.A.; Zain, S.K. Conversion of Lignocellulosic Biomass to Nanocellulose: Structure and Chemical Process. Sci. World J. 2014, 2014, 631013. [Google Scholar] [CrossRef]
- Smitha, B.; Sridhar, S.; Khan, A. Chitosan–sodium alginate polyion complexes as fuel cell membranes. Eur. Polym. J. 2005, 41, 1859–1866. [Google Scholar] [CrossRef]
- Siqueira, P.; Siqueira, E.; De Lima, A.E.; Siqueira, G.; Pinzón-Garcia, A.D.; Lopes, A.P.; Segura, M.E.C.; Isaac, A.; Pereira, F.V.; Botaro, V.R. Three-Dimensional Stable Alginate-Nanocellulose Gels for Biomedical Applications: Towards Tunable Mechanical Properties and Cell Growing. Nanomaterials 2019, 9, 78. [Google Scholar] [CrossRef] [Green Version]
- Wang, X.; Wang, Z.; Wang, X.; Shi, L.; Ran, R. Preparation of silver nanoparticles by solid-state redox route from hydroxyethyl cellulose for antibacterial strain sensor hydrogel. Carbohydr. Polym. 2021, 257, 117665. [Google Scholar] [CrossRef]
- Nagoba, B.; Selkar, S.; Wadher, B.; Gandhi, R. Acetic acid treatment of pseudomonal wound infections—A review. J. Infect. Public Health 2013, 6, 410–415. [Google Scholar] [CrossRef] [PubMed] [Green Version]
- Serra, R.; Grande, R.; Butrico, L.; Rossi, A.; Settimio, U.F.; Caroleo, B.; Amato, B.; Gallelli, L.; de Franciscis, S. Chronic wound infections: The role of Pseudomonas aeruginosaandStaphylococcus aureus. Expert Rev. Anti-Infect. Ther. 2015, 13, 605–613. [Google Scholar] [CrossRef] [PubMed]
- Zhou, L.; Chen, F.; Hou, Z.; Chen, Y.; Luo, X. Injectable self-healing CuS nanoparticle complex hydrogels with antibacterial, anti-cancer, and wound healing properties. Chem. Eng. J. 2021, 409, 128224. [Google Scholar] [CrossRef]
- Syafiq, M.A. Discovery of Antibacterial-Producing Actinobacteria from Selected Malaysian Mangrove Sediments. Master’s Thesis, Universiti Sains Malaysia, Penang, Malaysia, August 2018. [Google Scholar]
- Noh, N.A.M.; Abdullah, A.A.-A.; Ibrahim, M.N.M.; Yahya, A. Rhamnolipid produced by Pseudomonas aeruginosa USM-AR2 facilitates crude oil distillation. J. Gen. Appl. Microbiol. 2012, 58, 153–161. [Google Scholar] [CrossRef] [Green Version]
- Mohanta, Y.K.; Behera, S.K. Biosynthesis, characterization and antimicrobial activity of silver nanoparticles by Streptomyces sp. SS2. Bioprocess. Biosyst. Eng. 2014, 37, 2263–2269. [Google Scholar] [CrossRef]
- Liao, S.; Zhang, Y.; Pan, X.; Zhu, F.; Jiang, C.; Liu, Q.; Cheng, Z.; Dai, G.; Wu, G.; Wang, L.; et al. Antibacterial activity and mechanism of silver nanoparticles against multidrug-resistant Pseudomonas aeruginosa. Int. J. Nanomed. 2019, 14, 1469–1487. [Google Scholar] [CrossRef] [Green Version]

| Tested Bacteria | MIC Value (mg/mL) | ||
|---|---|---|---|
| bioAgNPs | Ampicillin | Streptomycin | |
| MRSA | 3.13 ± 0 | 0.016 | - |
| P. aeruginosa USM-AR2 | 6.25 ± 0 | - | 0.016 |
| Treatment (h) | Cell Line/LC50 Value (µg/mL) | |||
|---|---|---|---|---|
| DBTRG-05MG | SVGp12 | MCF7 | MCF10A | |
| 24 | 194.65 | >200 (n.d) | 194.53 | >200 (n.d) |
| 48 | 172.66 | >200 (n.d) | 172.66 | >200 (n.d) |
| 72 | 103.27 | >200 (n.d) | 103.27 | >200 (n.d) |
| Tested Compound | Diameter of the Inhibition Zone (mm) | |
|---|---|---|
| P. aeruginosa USM-AR2 | MRSA | |
| CNC/Alg | 0 | 0 |
| bioAgNP-CNC/Alg | 13 ± 0.7 | 11± 0 |
| streptomycin (+) | 10 ± 0.9 | - |
| vancomycin (+) | - | 17 ± 0 |
| dH2O (−) | 0 | 0 |
Publisher’s Note: MDPI stays neutral with regard to jurisdictional claims in published maps and institutional affiliations. |
© 2021 by the authors. Licensee MDPI, Basel, Switzerland. This article is an open access article distributed under the terms and conditions of the Creative Commons Attribution (CC BY) license (https://creativecommons.org/licenses/by/4.0/).
Share and Cite
Murugaiah, H.; Teh, C.L.; Loh, K.C.; Mohamad Yahya, A.R.; Md Noh, N.A.; Abu Bakar, N.H.H.; Kernain, D.; Hashim, R.; Bustami, Y. Study of Antibacterial and Anticancer Properties of bioAgNPs Synthesized Using Streptomyces sp. PBD-311B and the Application of bioAgNP-CNC/Alg as an Antibacterial Hydrogel Film against P. aeruginosa USM-AR2 and MRSA. Molecules 2021, 26, 6414. https://doi.org/10.3390/molecules26216414
Murugaiah H, Teh CL, Loh KC, Mohamad Yahya AR, Md Noh NA, Abu Bakar NHH, Kernain D, Hashim R, Bustami Y. Study of Antibacterial and Anticancer Properties of bioAgNPs Synthesized Using Streptomyces sp. PBD-311B and the Application of bioAgNP-CNC/Alg as an Antibacterial Hydrogel Film against P. aeruginosa USM-AR2 and MRSA. Molecules. 2021; 26(21):6414. https://doi.org/10.3390/molecules26216414
Chicago/Turabian StyleMurugaiah, Hemalatha, Chow Lun Teh, Kai Chew Loh, Ahmad Ramli Mohamad Yahya, Nur Asshifa Md Noh, Noor Hana Hanif Abu Bakar, Daruliza Kernain, Rokiah Hashim, and Yazmin Bustami. 2021. "Study of Antibacterial and Anticancer Properties of bioAgNPs Synthesized Using Streptomyces sp. PBD-311B and the Application of bioAgNP-CNC/Alg as an Antibacterial Hydrogel Film against P. aeruginosa USM-AR2 and MRSA" Molecules 26, no. 21: 6414. https://doi.org/10.3390/molecules26216414
APA StyleMurugaiah, H., Teh, C. L., Loh, K. C., Mohamad Yahya, A. R., Md Noh, N. A., Abu Bakar, N. H. H., Kernain, D., Hashim, R., & Bustami, Y. (2021). Study of Antibacterial and Anticancer Properties of bioAgNPs Synthesized Using Streptomyces sp. PBD-311B and the Application of bioAgNP-CNC/Alg as an Antibacterial Hydrogel Film against P. aeruginosa USM-AR2 and MRSA. Molecules, 26(21), 6414. https://doi.org/10.3390/molecules26216414

